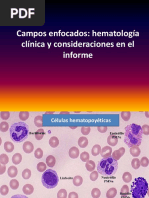

Fundamento de la tcnica
de Clulas L.E. y su
interpretacin
Tec. Lab. Irma Sifuentes F.
Un poco de historia .................
En 1949 Malcolm Hargraves, rodeado de inters por el conocimiento
del lupus, describe el fenmeno LE., constituyndose en la primera
evidencia de reactividad antinuclear. Posteriormente, el mismo
Hargraves describira el factor srico (que en el futuro serian los
anticuerpos anticlulas) al incubar plasma de un paciente con lupus
eritematoso sistmico agudo en un material tomado de la medula
sea de un enfermo con lupus, a la temperatura corporal y las
preparaciones concentradas, logrando observar as no slo las
clulas L.E., sino tambin el resto del fenmeno L.E. De esta manera
se inicio el conocimiento de los anticuerpos antinucleares.
En 1950 Klemper y cols. , jefe del departamento de
patologa del Monte Sinai, describe los cuerpos de
hematoxilina en diferentes tejidos provenientes de
autopsias de pacientes con lupus eritematoso
sistmico y plantea la hiptesis que las clulas L.E.
estn directamente relacionadas con la enfermedad,
observacin confirmada posteriormente en diversos
centros de la Unin Americana y Europa
En 1950 John R. Haserick, en la Cleveland Clinic, induce el
fenmeno L.E. a nivel experimental al utilizar medula sea de
pacientes no lpicos con suero de pacientes lpicos y de esta
manera propone que este factor es una globulina. En presencia
del factor srico, o globulina de acuerdo con Haserick y cols, los
ncleos de las clulas susceptibles sufran una alteracin
peculiar y eran posteriormente fagocitados por los
polimorfonucleares, al inducir la formacin de rosetas con los
leucocitos y la formacin de clulas L.E., adems el factor L.E
.desaparece de la sangre durante la remisin y reaparece durante
la recidiva de los pacientes con lupus eritematoso sistmico
agudo.
En 1951, 1952 y 1953, Rohn y Bond, utilizando
coloraciones supravitales, observaron con microscopio
de luz que los ncleos de los polimorfonucleares
primero se hinchaban y luego se produca la disolucin
de la cromatina, con una conversin del ncleo a una
masa amorfa. Zimmer en compaa de Hargraves
remplaza la medula sea por el "buffy coat" de sangre
perifrica para documentar el fenmeno L.E.
Prueba de Clulas L.E
Fundamento del mtodo
Las clulas L.E. clulas Hargraves son
polimorfonucleares que han fagocitado material
nuclear previamente alterado y procedente de la
destruccin del ncleo de otros leucocitos por el
llamado factor LE o factor nuclear (FN) . El factor LE
es una IgG anti-DNA que se fija a la superficie de del
ncleo y altera la cromatina nuclear.
El material nuclear alterado (cuerpo hematoxilnico)
de aspecto hialino, recubierto de anticuerpos y
complemento , es fagocitado con rapidez por los
polimorfoinucleares neutrofilos funcionalmente
activos
En un paciente que tiene alguna enfermedad del colgeno
(colagenosis) se da este fennmeno ejemplo en la artritis
reumatoidea, lupus, esclerodermia , etc.
Procedimiento
Colocamos a la sangre del paciente a incubar a 37 C para
de esta manera activar el factor L.E. que se encuentra en el
suero ,el cual es una globulina patolgica , un anticuerpo
agresor de tipo IgG antiDNA que al atacar al ncleo daa
la cromatina depolimerizando el ADN , induciendo a los
linfocitos a formar clulas L.E. Estos linfocitos queda
slo como una masa nuclear impregnado de factor L.E. y
complemento , de esta manera son facilmente fagocitados
por un neutrfilo funcionalmente activo .
Mecanismos de
autoinmunidad
Ataque celular
Anticuerpos
Fenmeno LE
+
+
Ncleo
celular
Material
nuclear
alterado
Polimorfonuclear
Clula L.E
Lisis celular
Factor L.E
IgG anti DNA
Cuerpo hialino
PMN
Clula
L.E
fagocitosis
Una celula L.E. constan de los sgtes componentes :
1.- Neutrofilo fagocitante
2.- Masa fagocitadada , no tiene ninguna estructura ,
de forma redonda u ovoide de color pardo prpura , es
un ncleo proveniente de un leucocito normal
L.E .en roseta : son varios neutrofilos
rodeando una masa hialina que al parecer
intenta fagocitar
Caracteristica principal de la
clula L.E.
Tcnica para clulas L.E
10 ml de sangre
coagulacin
Incubacin a
37C x 2 hrs
clula L.E
Centrifugacin
10 min. X
3500 rpm
centrifugacin
20 min.
X 5000
r.p.m
Machacado
del cogulo
Suero
Buffy coat
cogulo
Clula pre-L.E.
Neutrfilo con cambios
degenerativos y vacuolizacin
vacuola
Lbulos
hinchados
Clula L.E. tpica
Monocito con ncleo
picntico fagocitado
(clula tarta)
Clula L.E. Neutrfilo segmentado
con material fagocitado
Clula pre-L.E.
Neutrfilo segmentado con cambios
lticos nucleares y mayor
vacuolizacin
Lisis nuclear y
vacuolizacin
Clula pre-L.E.
Neutrfilo con cambios
degenerativos e hinchazn
lobular
Roseta L.E
Neutrfilos
Masa
nuclear
lisada
Clula L.E. tpica
Clula L.E. Neutrfilo segmentado
con material fagocitado